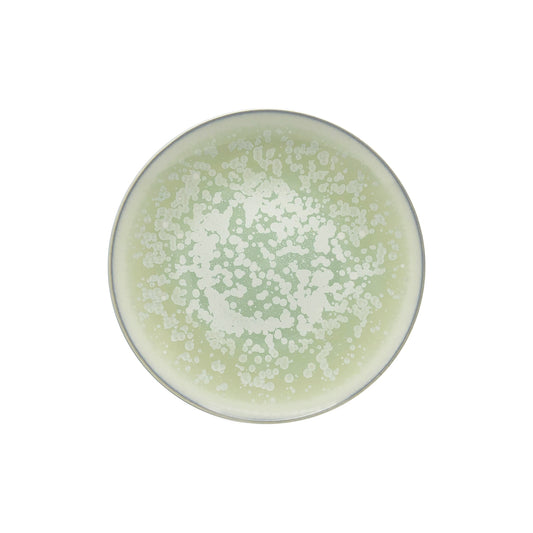
JL Coquet  SONG Amande - Assiette ? dessert, Agora 8.27 Inch SKU: AGO1028SGAMCREM000
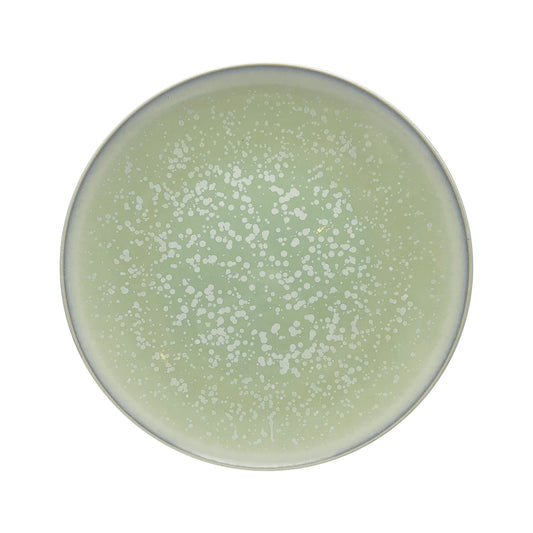
JL Coquet  SONG Amande - Assiette plate, Agora 10.63 Inch SKU: AGO1034SGAMCREM000
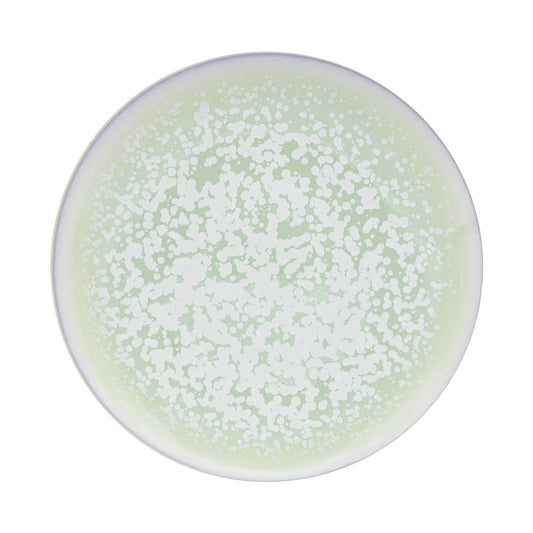
JL Coquet  SONG Amande - Assiette 29 cm, Agora 11.42 Inch SKU: AGO1002SGAMCREM000

Collection: Products
-
JL Coquet SONG Amande - Charger plate, 2011 12.99 Inch SKU: DMO1039SGAMCREM000
Regular price $291.03 USDRegular price -
JL Coquet SONG Amande - Charger plate, Agora 12.6 Inch SKU: AGO1039SGAMCREM000
Regular price $252.54 USDRegular price -
JL Coquet SONG Amande - Charger plate, Bowlro 12.6 Inch SKU: Bowl1039SGAMCREM000
Regular price $279.00 USDRegular price -
JL Coquet SONG Amande - Cloche, Wide Rim soup plate 4.92 Inch SKU: HOR1047SGAMCREM000
Regular price $194.82 USDRegular price -
JL Coquet SONG Amande - Dessert plate, 2011 5.51 Inch SKU: DMO1028SGAMCREM000
Regular price $177.98 USDRegular price -
JL Coquet SONG Amande - Dessert plate, Agora 8.27 Inch SKU: AGO1028SGAMCREM000
Regular price $151.52 USDRegular price -
JL Coquet SONG Amande - Dessert plate, Bowlro 4.33 Inch SKU: Bowl1028SGAMCREM000
Regular price $190.00 USDRegular price -
JL Coquet SONG Amande - Dinner plate, 2011 10.63 Inch SKU: DMO1034SGAMCREM000
Regular price $202.03 USDRegular price -
JL Coquet SONG Amande - Dinner plate, Agora 10.63 Inch SKU: AGO1034SGAMCREM000
Regular price $177.98 USDRegular price -
JL Coquet SONG Amande - Dinner plate, Bowlro 10.63 Inch SKU: Bowl1034SGAMCREM000
Regular price $214.06 USDRegular price -
JL Coquet SONG Amande - Mug 9.13 OZ SKU: HOR3004SGAMCREM000
Regular price $158.74 USDRegular price -
JL Coquet SONG Amande - Plate 29 cm 15, 2011 11.42 Inch SKU: DMO1004SGAMCREM000
Regular price $233.31 USDRegular price -
JL Coquet SONG Amande - Plate 29 cm, Agora 11.42 Inch SKU: AGO1002SGAMCREM000
Regular price $214.06 USDRegular price -
JL Coquet SONG Amande - Plate 29 cm, Bowlro 11.42 Inch SKU: Bowl1002SGAMCREM000
Regular price $240.52 USDRegular price -
JL Coquet SONG Amande - Plate a pates MM 9.45 Inch SKU: HOR1009SGAMSGAM000
Regular price $177.98 USDRegular price -
JL Coquet SONG Amande - Plate a pates PM 8.27 Inch SKU: HOR1010SGAMSGAM000
Regular price $167.91 USDRegular price